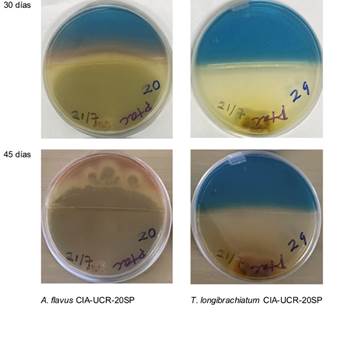
Placas Petri con medio CAS-azul (parte superior) y PDA (parte inferior) con los hongos Aspergillus flavus (izquierda) y Trichoderma longibrachiatum (derecha).

Artículo
Incremento de la fijación biológica de nitrógeno y el crecimiento de la soya (Glycine max) mediante el uso de hongos solubilizadores de fósforo
Increase the biological nitrogen fixation and the growth of soybean (Glycine max) using phosphorus-solubilizing fungi
Incremento de la fijación biológica de nitrógeno y el crecimiento de la soya (Glycine max) mediante el uso de hongos solubilizadores de fósforo
Agronomía Costarricense, vol. 48, núm. 1, pp. 93-109, 2024
Universidad de Costa Rica. Colegio de Ingenieros y Agrónomos. Ministerio de Agricultura y Ganadería
Recepción: 25 Julio 2023
Aprobación: 02 Octubre 2023
Resumen: Introducción. La soya establece una simbiosis con Bradyrhizobium japonicum para fijar N atmosférico. La coinoculación con otros microorganismos promotores del crecimiento (MPC) puede incrementar la Fijación Biológica de Nitrógeno (FBN) y el crecimiento de las plantas. Objetivo. Determinar si la inoculación con los hongos solubilizadores de P (SP), Aspergillus flavus (S1) y Trichoderma longibrachiatum (S2), afecta variables de crecimiento y de FBN en soya. Materiales y métodos. En un Andisol y un Ultisol en invernadero, se evaluaron variables de crecimiento y FBN en soya inoculada con B. japonicum y 2 SP. Se evaluaron 5 tratamientos: un testigo absoluto (T), adición de roca fosfórica (RF), adición de RF e inoculación con B. japonicum (BRF) y la adición de RF, B. japonicum y los 2 SP de manera independiente (BRFS1 y BRFS2). Se estableció un diseño irrestricto al azar con 4 repeticiones y los datos se analizaron según la normalidad, con ANDEVA y DGC al 5% o Kruskal Wallis al 5%. Resultados. Se obtuvo un efecto positivo sobre las variables evaluadas, cuando la soya se inoculó con los SP además de B. japonicum. El efecto fue tendencia en el Andisol, para las variables peso fresco aéreo y número de nódulos y su peso seco, mientras que para el Ultisol se encontró significancia para estas mismas variables, así como para el peso seco aéreo, área foliar y contenido de N y P foliar, el efecto fue mayor en BRFS2. En términos absolutos el mayor contenido de P en la biomasa microbiana del suelo y la mayor población de SP se encontró en el tratamiento con la presencia de S2. Las poblaciones de Fijadores de N fueron mayores para T y RF. Conclusión. La inoculación con hongos SP puede afectar positivamente la FBN, las cantidades de N y P foliar así como el crecimiento de las plantas de soya.
Palabras clave: Solubilizadores de P, Bradyrhizobium, sostenibilidad, FBN, consorcio microbiano, sideróforos.
Abstract: Introduction. Soybean establishes a symbiosis with Bradyrhizobium japonicum that allows it to fix atmospheric N. Coinoculation with other plant growth-promoting microorganisms can increase Biological Nitrogen Fixation (BNF) and plant growth. Objective. Determine if inoculation with P-solubilizing fungi (SP), Aspergillus flavus (S1) and Trichoderma longibrachiatum (S2), affects growth and BNF variables in soybeans. Materials and methods. In the greenhouse on an Andisol and an Ultisol, growth variables and BNF were evaluated in soybeans inoculated with B. japonicum and 2 SPs. Five treatments were evaluated: an absolute control (T), addition of phosphate rock (RF), addition of RF and inoculation with B. japonicum (BRF) and the addition of RF, B. japonicum and the 2 SPs independently (BRFS1 and BRFS2). An unrestricted randomized design with 4 repetitions was established and the data was analyzed according to normality, either with ANDEVA and DGC at 5% or Kruskal Wallis at 5%. Results. The responses obtained showed a positive effect on the evaluated variables when soybeans were inoculated with SP in addition with B. japonicum. The effect was a trend in Andisol, for the variables aerial fresh weight and number of nodules and their dry weight, while for Ultisol significance was found for these same variables, as well as for aerial dry weight, leaf area and N content and foliar P, with the greatest effect in BRFS2. In absolute terms, the highest P content in the soil microbial biomass and the highest SP population was found in the treatment with the presence of S2. The populations of N Fixers (NF) in the soil were higher for T and RF that did not have inoculation with B. japonicum. Conclusion. Inoculation with SP fungi can positively affect BNF, foliar N and P amounts as well as soybean plant growth.
Keywords: P solubilizers, Bradyrhizobium, sustainability, BNF, microbial consortium, siderophores.
Introducción
El N y el P son nutrientes esenciales para el crecimiento de las plantas y el soporte de la vida en su conjunto. La disponibilidad de estos nutrientes está regulada en los ecosistemas, a través de procesos complejos relacionados con los ciclos biogeoquímicos, y son mediados de una u otra manera por una alta diversidad de poblaciones microbiológicas (Parewa et al. 2018) interrelacionadas, interdependientes y autoorganizadas (Morin 2002).
En el caso del N, la atmósfera está compuesta por 78,08% de N2, un gas inerte que en condiciones naturales es prácticamente no disponible para plantas y animales (Islam et al. 2017) y solo puede ser disponibilizado por bacterias y arqueas en los ambientes bióticos. Después de que Fritz Haber y Carl Bosch descubrieron, en las primeras décadas del siglo XX, la forma de sintetizarlo de la atmósfera, la tecnología se ha utilizado en la fabricación de fertilizantes nitrogenados. Esto ha permitido aplicar grandes cantidades de N soluble en los suelos agrícolas y aumentar ampliamente el rendimiento de los cultivos. Sin embargo, de manera asociada el uso de esta tecnología ha contribuido de forma muy significativa con la contaminación de mantos acuíferos, la eutrofización, la desestabilización de las poblaciones naturales, la producción de gases de efecto invernadero, la lluvia ácida (Savci 2012) y los daños a la salud humana (El-Nahhal 2018). Además el proceso demanda mucha energía y requiere quemar toneladas de gas natural y contar con reactores de acero de paredes gruesas para contener la presión necesaria. Por otro lado, el proceso industrial está muy cercano a los límites tecnológicos, lo que deja casi sin espacio a las mejoras adicionales mediante la optimización tecnológica (Cherkasov et al. 2015).
En el caso del P, además del impacto ecológico negativo de su uso como fertilizante soluble, que incluye la contaminación de mantos acuíferos, la eutrofización, la desestabilización de las poblaciones naturales, entre otras (Schindler et al. 2008), este nutriente impone un límite físico insoslayable a la agricultura industrial, ya que el cenit de los yacimientos fosfóricos se estima para la década del 2030-2040, lo que limitará inevitablemente la producción de fertilizantes fosforados de síntesis química (Fernández y González-Reyes 2014).
En los últimos años, la productividad de muchos cultivos se ha reducido, debido a la degradación de la calidad y salud de los suelos y los ecosistemas en general. Una de las causas principales de esta problemática es el uso continuo de fertilizantes químicos solubles, sobre todo de N y P (Savci 2012). Hay consenso en que esta práctica tiene un efecto nocivo sobre el suelo y los ecosistemas en general (Savci 2012, Parewa et al. 2018), por lo que es urgente encontrar nuevas vías para solventar la nutrición de las plantas. La producción sostenible de cultivos agrícolas sólo podrá lograrse mediante la aplicación de técnicas que no deterioren la salud del suelo y los ecosistemas (Parewa et al. 2018, Singh et al. 2016), cualquier otra vía no podrá ser sostenible en una biosfera finita.
Debido a esto, existe un creciente interés para reducir la dependencia en la fertilización química, con el establecimiento de prácticas agrícolas que aprovechen y se integren con los procesos y ciclos naturales (Giraldo 2015) para mantener la calidad y salud de los suelos. La inoculación de plantas con microorganismos con capacidad biofertilizante es una práctica acorde con la puesta en marcha de un nueva racionalidad, que entiende que la agricultura, además de producir bienes agrícolas como alimentos y fibras, tiene un impacto directo sobre la estabilidad dinámica de los ecosistemas, la sostenibilidad ambiental, y el bienestar animal y humano (Kibblewhite et al. 2008; Giraldo y Toro 2020).
Los microorganismos del suelo que se asocian a las plantas y presentan efectos benéficos para su desarrollo, han sido denominado microorganismos promotores del crecimiento vegetal (MPCV), dentro de ellos se encuentran los conocidos como biofertilizantes. Los biofertilizantes representan una herramienta para mejorar la nutrición de las plantas, ya que posibilitan la disponibilidad de nutrientes, así como una mejor eficiencia de su uso, sin causar daños en los ecosistemas (Singh et al. 2016).
Los biofertilizantes incluyen, entre otros, los microorganismos solubilizadores de fósforo (SP) y las bacterias fijadores de N (FN). En cuanto a las FN se encuentran tanto las de vida libre como el género Azotobacter, las asociadas a la rizosfera como el género Azospirillum y las que establecen asociaciones simbióticas endofíticas con plantas como las leguminosas y forman estructuras radicales especializadas para la fijación del N atmosférico, conocidas como nódulos (Parewa et al. 2018). Este último es el caso de la relación simbiótica entre la bacteria Bradyrhizobium japonicum y la soya.
Las bacterias FN en toda su diversidad, forman parte integral de sistemas vivos concretos y ecosistemas y son reconocidas como responsables de la mayor parte de la fijación del nitrógeno atmosférico, por medio del proceso conocido como Fijación Biológica de Nitrógeno (FBN) (Soumare et al. 2020). Al contrario del proceso industrial Haber-Bosch, la FBN tiene lugar imperceptiblemente a temperatura y presión ambiente, por esto desde el punto de vista ambiental se muestra como un proceso de autorregulación sistémica que no tiene problemas ambientales asociados (Cherkasov et al. 2015).
Los géneros de Rhizobium y Bradyrhizobium han sido utilizados como inoculantes en la agricultura, en la producción de leguminosas de interés para el consumo humano y animal. Entre los que destaca el cultivo de la soya (Glycine max) y una gran variedad de frijoles (Phaseolus sp.) que producen biomasa y grano, así como también leguminosas utilizadas para la producción de forrajes, coberturas y abonos verdes (Hungria et al. 2013).
Las leguminosas tienen un papel fundamental en el desarrollo de estrategias para asegurar una producción agrícola sin afectar negativamente el medio ambiente, ya sea por la producción directa de los cultivos de leguminosas o por la utilización de los residuos de cosecha que pueden incorporarse al suelo superficialmente y/o ser aprovechados en asociaciones y rotaciones, como fuente de N para el suelo y otros cultivos (Islam et al. 2017).
Las asociaciones simbióticas entre las leguminosas y Rhizobium pueden reducir alrededor de 70 millones de toneladas por año de N atmosférico a amoníaco; esta cantidad representa el 40% del total del N fijado biológicamente, el 60% restantes es fijado por bacterias en asociación en la rizosfera o aquellas de vida libre (Islam et al. 2017).
El cultivo de la soya en asociación con Bradyrhizobium puede fijar hasta 300 kg.ha-1.año-1 de N atmosférico para su crecimiento y a la vez enriquecer la fertilidad y el contenido de materia orgánica del suelo (Rattan et al. 2017, Soumare et al. 2020, Islam et al. 2017).
Para el caso particular de la soya, el establecimiento de la simbiosis es fundamental para lograr una producción adecuada, por lo que la inoculación con cepas de B. japonicum eficientes ha sido bastante estudiada (Rahmani et al. 2000, Kazemi et al. 2005, Saranraj et al. 2021, Edson Zilli et al. 2021). Maluk et al. (2023) indican que la capacidad de FBN de la soya nodulada se puede utilizar para proporcionar la mayoría de los requisitos de N de la planta, pero requiere la inoculación con cepas de Bradyrhizobium no nativas, ya que la falta de inoculación da como resultado reducciones significativas tanto en el rendimiento como en la calidad del grano.
La investigación sobre la contribución de la inoculación múltiple de biofertilizantes en la producción de soya es menos abundante y se ha prestado menor atención al efecto combinado de la inoculación con microorganismos SP. El P, a pesar de ser abundante en los suelos tanto en formas inorgánicas como orgánicas, es poco disponible para las plantas en muchos de los suelos agrícolas en todo el mundo e incluso en suelos considerados como fértiles, generalmente no es suficiente debido a su poca disponibilidad (Gyaneshwar et al. 2002). El P es requerido para procesos tan importantes como la fotosíntesis, la FBN, el desarrollo de la raíz, la floración, la formación de semillas, la fructificación y la mejora de la calidad de los cultivos (Lamyaa et al. 2019).
Debido a la inmovilización en los suelos la eficiencia del uso de fertilizantes fosfóricos en todo el mundo es de alrededor de 10-25% y la concentración de fósforo disponible (aniones de ortofosfatos) para las plantas en la solución del suelo es muy baja y alcanza el nivel de 1 a 5 (M (Gyaneshwar et al. 2002, Richardson et al. 2009, Islam et al. 2017, Lamyaa et al. 2019).
Los microorganismos pueden biodisponibilizar el P nativo del suelo, así como fuentes adicionadas como la roca fosfórica (RF). La biodosponibilidad de P por los microorganismos se atribuye principalmente a la solubilización por excreción de ácidos orgánicos, sin embargo, otros procesos como la producción de sideróforos están involucrados (Hallama et al. 2019, Rawat et al. 2021, Basílio et al. 2022). De esta manera, estos microorganismos son capaces de transformar el P fijado o no disponible en el suelo, a formas disponibles para la planta. Paralelamente, la biomasa microbiana puede asimilar el P soluble y evitar que se fije en la fase mineral del suelo, y de esta forma permanece biodisponible (Patiño-Torres y Sanclemente-Reyes 2014, Islam et al. 2017, Lamyaa et al. 2019, Rawat et al. 2021).
El P es requerido en cantidades apropiadas por todos los cultivos, pero para las leguminosas su presencia es muy relevante, ya que la FBN es un proceso altamente demandante de energía y por tanto, dependiente de una cantidad adecuada de P disponible, el cual forma parte de la molécula de adenosín trifosfato (ATP), principal transportador energético para la mayoría de los procesos celulares incluyendo la FBN (Kleinert et al. 2014, Li et al. 2020, Lamyaa et al. 2019, Islam et al. 2017).
Se ha observado que la co-inoculación de cepas de Rhizobium junto con otros MPCV, como los solublizadores de P, permite una mayor FBN y un mejor crecimiento y producción de las plantas, debido posiblemente a una nutrición más adecuada y/o a otros efectos promovidos por la interacción de los microorganismos inoculados y sus relaciones con el entorno, dentro del concepto de holobionte (Cassan et al. 2009, Zarei et al. 2012, Parewa et al. 2018, Lyu et al. 2021). De esta manera, los microorganismos que fijan N y aquellos que solubilizan P presentan potencial para ser utilizadas como parte de un sistema general de gestión agrícola, que permita reducir el uso de fertilizante sintético (Parewa et al. 2018, Islam et al. 2017).
En esta investigación, se evaluó a nivel de invernadero y en suelos (Andisol y Ultisol) de Costa Rica, el efecto de la inoculación con los hongos nativos, Aspergillus flavus (CIA-UCR-20SP) y Trichoderma longibrachiatum (CIA-UCR-29SP), descritos previamente como SP por Vargas y Castro (2019), sobre el crecimiento y la nutrición nitrogenada y fosfórica de las plantas de soya y la relación simbiótica que establece con Bradyrizobium japonicum. Esto con el fin de explorar técnicas agroecológicas particulares y locales que puedan insertarse dentro de un manejo agrícola sostenible.
Materiales y métodos
Los ensayos se realizaron en el invernadero del Laboratorio de Microbiología Agrícola del Centro de Investigaciones Agronómicas de la Universidad de Costa Rica (LMA-CIA-UCR). Se utilizaron 2 suelos un Andisol de Rancho Redondo, San José y un Ultisol de Sarapiquí, Heredia. Los respectivos análisis de suelo se muestran en la Tabla 1. Cada suelo por separado se homogenizó y se colocaron en recipientes de 4 litros de capacidad.

Para la siembra de cada unidad experimental, se utilizó 2 semillas de soya de la variedad para grano y forraje CIGRAS-UCR-06 y se inocularon según el tratamiento, con 3 cepas de Bradyrhizobium japonicum en mezcla (CIA-UCR-506, CIA-UCR-508 y CIA-UCR-514), Aspergillus flavus (cepa CIA-UCR-20SP) (S1) y Trichoderma longibrachiatum (cepa CIA-UCR-29SP) (S2), hongos previamente identificados (Vargas y Castro 2019) por técnicas moleculares en el Centro de Investigación en Protección de Cultivos de la UCR (CIPROC-UCR), además Vargas y Castro (2019) describen su potencial como SP. Ocho días antes de la siembra se aplicó a los tratamientos que así lo requerían 8 g de roca fosfórica 33% P.maceta-1.
La inoculación con B. japonicum se realizó directamente a la siembra con la aplicación de 10 ml a cada semilla de una solución con una población de 108 UFC.ml-1. La mezcla bacteriana se suspendió en agua esterilizada, a partir del crecimiento en placas Petri con el medio agar levadura manitol (ALM). Los hongos se aplicaron cuando las plantas emergieron del suelo (10 días después de la siembra) y se realizó una segunda aplicación 24 días después de la siembra. Los hongos se aplicaron también en una solución acuosa con una concentración 106, la suspensión en agua se realizó a partir del crecimiento sobre placas de Petri con medio papa dextrosa agar (PDA) y se aplicaron 50 ml de la solución en forma de “drench” alrededor de cada planta, para un total de 100 ml por maceta.
Los ensayos se organizaron de manera independiente en un diseño experimental irrestricto al azar con 4 repeticiones y los 5 tratamientos siguientes: un testigo absoluto (T), adición de roca fosfórica (RF), adición de RF e inoculación con B. japonicum (BRF), y la adición de RF, B. japonicum y los 2 SP independientemente (BRFS1 y BRFS2) (Figura 1A). Luego de comprobar la normalidad de los datos (Shapiro-Wilks), se analizaron con ANDEVA y DGC (p<0,05) y con Kruskal Wallis al 5% de significancia.
Los ensayos fueron evaluados en la etapa fenológica 50% de floración. Se separó la parte aérea y la parte radical y al tejido foliar se le determinó el peso fresco y se llevó a un horno con temperatura de 60oC por 48 horas, hasta alcanzar el peso seco que fue medido. A la parte radical se le determinó el peso fresco y se extrajeron los nódulos presentes, los mismos fueron colocados en contenedores metálicos para ser contados y pesados (Figura 1B), ambos materiales fueron llevados al horno por 48 horas y se les determinó el peso seco.

Los pesos secos y frescos de los tejidos vegetales fueron determinados en una balanza granataria digital marca Sartorios, mientras que para los nódulos se utilizó una balanza analítica digital Explorer de OHAUS.
Las variables evaluadas en el Andisol para determinar el efecto sobre el crecimiento de las plantas fueron: el peso fresco y seco tanto foliar como radical (PFA, PSA, PFR, PSR). Mientras que, para determinar el efecto sobre las variables de FBN, se determinó el número de nódulos y el peso fresco y seco (PFN: Peso fresco de nódulos y PSN: Peso seco de nódulos) de estos. En el Ultisol, se midieron estas mismas variables, pero como se observaron diferencias en el tamaño y el color de las hojas en los diferentes tratamientos, se evaluó el área foliar, de la hoja más grande presente en las 6 hojas más jóvenes completamente desarrolladas. Así también, se determinó la concentración de N y P foliar por los métodos descritos por Díaz y Hunter (1978) y Henríquez y Cabalceta (2012) aplicados en el Laboratorio de Suelos y Foliares del Centro de Investigaciones Agronómicas de la Universidad de Costa Rica (LSF-CIA-UCR). Las variables de FBN evaluadas fueron las mismas que en el Andisol.
En el Ultisol se evaluó, en el LMA-CIA-UCR, las poblaciones de solubilizadores de fósforo, fijadores de Nitrógeno y la biomasa microbiana de P en el suelo. Para determinar las poblaciones, se realizaron diluciones seriadas y recuentos viables (MLA-CIA-UCR 2015). Para las poblaciones de FN, se determinaron las unidades formadoras de colonias (UFC) mediante el recuento en el medio fijadores de N (FN) (MLA-CIA-UCR 2015). Las poblaciones de SP, se determinaron según la técnica del número más probable (NMP) (MLA-CIA-UCR 2015), con el medio de crecimiento propuesto por Osorio y Habte (2001) y la metodología utilizada por Vargas y Castro (2019). La determinación de biomasa microbiana de P en el suelo se realizó mediante el procedimiento de extracción-fumigación de Vance et al. (1987) y el P en solución se determinó en LSF-CIA-UCR por Espectroscopia de Emisión Óptica de Plasma Acoplado Inductivamente (ICP-OES).
De manera complementaría se determinó la capacidad de producción de sideróforos de las cepas Aspergillus flavus (cepa CIA-UCR-20SP) y Trichoderma longibrachiatum (cepa CIA-UCR-29SP), por medio de la metodología propuesta por Milagres et al. (1999), la cual determina un viraje de color del medio Cromo azurol S agar (CAS-azul), de azul a colores rojizos o naranjas, esto debido al secuestro del Fe, por los sideróforos producidos por el microorganismo. Debido a que el medio CAS-azul es tóxico para muchos microorganismos, se preparan placas Petri con el medio indicado para el microorganismo a evaluar y el medio CAS-azul. Para este caso los hongos se colocaron para su crecimiento en PDA que ocupó el 50% de la placa y el viraje de color se evaluó en el medio CAS-azul que ocupó el otro 50%.
Resultados y discusión
En ambos suelos, se observó un efecto positivo de la inoculación con los hongos Aspergillus flavus (S1) y Trichoderma longibrachiatum (S2) sobre variables de crecimiento y FBN en el cultivo de la soya. Para el Andisol esta respuesta fue tendencia, y para el Ultisol fue estadísticamente significativa.
En cuanto al Andisol (Tabla 2), el tratamiento T mostró el menor PFA con 18,58 g y los 2 tratamientos con SP los mayores pesos (22,93 y 22,4 g) sin ser estos estadísticamente diferentes a los tratamientos TRF y BRF (20,73 y 21,31 g). Las variables PSA, PFR y PSR no mostraron diferencias significativas entre los tratamientos. En las variables de FBN el tratamiento T y TRF obtuvieron los menores valores para la variable número de nódulos (5,5 y 11), ya que en este caso no hubo inoculación con Bradyrhizobium y los nódulos formados fueron producto de la nodulación con cepas presentes en el suelo. Estos nódulos eran grandes, redondeados, pero poco esféricos, el color interno claro y ubicados en las raíces periféricas (Figura 2A). Los tratamientos BRFS1 y BRFS2 mostraron el mayor número de nódulos (73,25 y 79,75) mientras que el tratamiento BRF presentó un comportamiento intermedio para esta variable con 64,25 nódulos. Estos últimos 3 tratamientos mencionados mostraron nodulación en la base de la raíz y los nódulos eran más pequeños, esféricos (Figura 2B) y rojos en su interior, lo que indica la presencia activa de leghemoglobina, proteína involucrada en la regulación de la concentración de oxígeno dentro del nódulo e indicadora de la fijación por parte de la enzima nitrogenasa (Lloret-Pastor 2021). La posición espacial de los nódulos, en la base radical, es usual en la nodulación producto de la inoculación, ya que la infección con la bacteria se da en los primeros estados de la germinación de la semilla.

Letras diferentes en la misma columna muestran diferencias estadísticas entre medias, según DGC al 5% o Kruskal Wallis al 5% (1 y 2 respectivamente).

Para las variables PFN y PSN, el tratamiento T mostró los menores valores, los otros tratamientos no presentaron diferencias significativas, pero la tendencia fue encontrar los mayores pesos en los tratamientos BRFS1 y BRFS2, los cuales contenían, además de la cepa de Bradyrhizobium, los hongos Aspergillus flavus (S1) y Trichoderma longibrachiatum (S2) (Tabla 2).
En el Ultisol, se encontraron diferencias significativas en las variables PFA, PSA, PFN, PSN, número de nódulos, área foliar y concentración de P y N foliar. Para el peso fresco aéreo (Figura 3), los tratamientos T, TRF y BRF mostraron el menor peso foliar con pesos entre 15 y 19,24 g; mientras que los tratamientos BRFS1 y BRFS2 mostraron los mayores pesos frescos foliares con valores de 23,77 y 25,78 g, respectivamente. El peso seco aéreo (Figura 3) mostró el mismo comportamiento, en este caso, los tratamientos T, TRF y BRF mostraron pesos entre 4,49 y 5,50 g y los tratamientos con Aspergillus flavus (S1) y Trichoderma longibrachiatum (S2) valores significativamente mayores de 6,53 y 7,08 g para S1 y S2 respectivamente.

Para las variables PFN y PSN (Figura 4), los tratamientos se distribuyeron en aquellos que presentaron los valores más bajos, que fueron el T y el TRF con 31,7 y 16,9 mg para el peso fresco, y 8 y 5 mg para el seco respectivamente. Así como, los tratamientos con los valores estadísticamente más altos que fueron BRF con valores de189 y 63 mg, y BRFS1 y BRFS2 con valores de 230 y 252,7 mg en peso fresco y 69 y 80 mg en peso seco.

Letras diferentes en las columnas según el eje muestran diferencias estadísticas entre medias, según DGC al 5% para el peso fresco y Kruskal Wallis al 5% para el peso seco.
Para la variable número de nódulos (Figura 5A), el comportamiento fue similar al observado en el suelo Andisol, tanto a las tendencias como en lo que se apuntó con respecto al tamaño, color y posición de los nódulos. En este caso, los tratamientos T y RF presentaron la menor cantidad de nódulos con un máximo de 2 nódulos, el tratamiento BRF presentó un valor de 35,5 nódulos y valor intermedio de significancia, mientras que los tratamientos con Aspergillus flavus (BRFS1) y Trichoderma longibrachiatum (BRFS2) presentaron significativamente la mayor cantidad de nódulos con valores entre 48,75 y 52,75.

Letras diferentes en las columnas muestran diferencias estadísticas entre medias, según DGC al 5% para el área foliar y Kruskal Wallis al 5% para el número de nódulos.
La variable área foliar (Figura 5B) presentó diferencias más diversas, en este caso, T y BRF mostraron los valores más bajos (55,18 y 63,62 cm2), los tratamientos RF y BRFS1 con valores de 78,54 y 94,03 cm2 respectivamente y el mayor valor para esta variable lo obtuvo el tratamiento BRFS2 con un valor de 112,63 cm2. Para esta variable se observa una reducción en la superficie foliar cuando se realiza la inoculación con Bradyrhizobium en presencia RF, pero sin los solubilizadores de P. En términos de valores absolutos, tanto BRFS1 como BRFS2, mostraron los valores más altos.
Con respecto al contenido de N foliar (Figura 6) los tratamientos con Aspergillus flavus (BRFS1) y Trichoderma longibrachiatum (BRFS2) mostraron los valores más altos con 177 y 188 mg.planta-1 respectivamente, mientras que el resto de los tratamientos mostraros valores más bajos entre 134 y 155 mg.planta-1 (Figura 6). Los tratamientos no inoculados con Bradyrhizobium presentaron desde el inicio de la floración, hojas superiores amarillas, en contraste con los tratamientos inoculados (Figura 7). Para el contenido de P, destacó BRFS2 con el mayor valor (6,3 mg.planta-1) seguido por BRFS1 con un valor intermedio en significancia de 5,2 mg.planta-1, mientras que los tratamientos T, RF, BRF presentaron los menores valores (entre 3,8 y 4,4 mg.planta-1) (Figura 6).

En relación con los resultados anotados anteriormente, Rosas et al. (2002) y Olivera et al. (2002) indican que la inoculación combinada de soya con B. japonicum y microorganismos SP (en este caso bacterias), aumentó el peso seco de las plantas, este resultado coincide con los resultados obtenidos en esta investigación. Por su parte, Lamyaa et al. (2019) y Stajković-Srbinović et al. (2021) mostraron que la aplicación de fuentes fosfóricas, junto con bacterias SP también incrementó el rendimiento de grano y la biomasa seca de la soya y posibilitaron una mejor absorción de nutrientes, comparado con la aplicación del fósforo solo, lo que concuerda con los resultados de la presente investigación, en donde, en el caso del Ultisol se obtuvo un aumento foliar de aproximadamente 20% en el contenido de N y 30% en el contenido de P, cuando se utilizaron los hongos solubilizadores junto con la aplicación de roca fosfórica, mostrando la necesidad de la mediación microbiología para la obtención de estos nutrientes por la planta. En este mismo sentido, Cao et al. (2017) también indicaron aumentos significativos en el rendimiento de la soya, debido a la co-inoculación con bacterias solubilizadoras de fósforo. Mientras que Sukiman et al. (2019) observaron resultados similares al inocular hongos micorrízicos junto con Bradyrhizobium.

Hay poca información para soya, específicamente respecto a la utilización de hongos filamentosos como Aspergillus flavus (S1) y Trichoderma longibrachiatum (S2), utilizados en esta investigación. El-Nahrawy et al. (2020) mostraron que en condiciones de déficit hídrico la cepa de Trichoderma que utilizaron afectó positivamente a la soya nodulada con B. japonicum. Las personas autoras indican que el hongo actuó como estimulador del desarrollo vegetativo y aumentó el contenido de N foliar y pigmentos fotosintéticos y proponen que un consorcio microbiano adecuado de Bradyrhizobium y Trichoderma podría representar un método práctico y prometedor para aumentar la productividad de la soya y otras leguminosas agronómicamente importantes; sin embargo, no indican que la cepa de Trichoderma utilizada fuera solubilizadora de P. Por su parte da Costa Leite et al. (2023) reportan incrementos en variables de crecimiento y producción de la soya inoculada con Bradyrhizobium sp., Trichoderma asperellum y Bacillus amyloliquefaciens, pero tampoco detallan las propiedades solubilizadoras de P de la cepa de Trichoderma utilizada.
Para las variables biomasa microbiana de P y las poblaciones de FN y SP evaluadas en el suelo de las unidades experimentales (Tabla 3), se observa que, aunque no se encontraron diferencias significativas, en términos absolutos el mayor contenido de P en la biomasa microbiana se encontró en el tratamiento con la inoculación de Trichoderma longibrachiatum (S2) así como, la mayor población de solubilizadores de P. Además, por reaislamiento se determinó que el microorganismo con mayor abundancia era S2. En el caso de las poblaciones de FN, se observó una tendencia a una población mayor en los tratamientos que no fueron inoculados con B. japonicum, lo que indica un posible efecto antagónico entre B. japonicum y otras cepas fijadoras de N presentes. Este efecto podría corresponder a regulaciones ecosistémicas de las poblaciones microbiológicas del suelo relacionadas con la FBN (Smercina et al. 2019).

Las diferencias encontradas en la significancia estadística entre ambos suelos, que mostraron solo una tendencia para el suelo Andisol, mientras que fueron estadísticamente significativa en el Ultisol, se pueden relacionar con la mayor cantidad de P disponible en el Andisol (Tabla 1). Este elemento es necesario en el proceso de FBN, al menos para la gestión energética ya que se requieren 16 moles de ATP para reducir una molécula de N2 atmosférico (Sun et al. 2021, Lloret-Pastor 2021). Como tal elemento era disponible a una mayor concentración para la planta en el Andisol, las diferencias entre los tratamientos fueron menores y no claramente definidos por el análisis estadístico. En el mismo sentido, el tamaño y la coloración de las hojas no mostraron diferencias evidentes en el Andisol, mientras que en el Ultisol, las diferencias en la coloración fueron contrastantes visualmente (Figura 5B, Figura 7). Esto indicó la deficiencia de N en los tejidos jóvenes en los tratamientos T y TRF que mostraron un color amarillo. Esta coloración se corrigió, con la aplicación de Bradyrhizobium en el tratamiento BRF, pero la adición de los hongos solubilizadores Aspergillus flavus (BRFS1) y Trichoderma longibrachiatum (BRFS2) incrementó significativamente el valor de los contenidos de N y P en las plantas (Figura 6), así como el tamaño de las hojas al comparar estos tratamientos con el BRF (Figura 5B).
Respecto a la producción de sideróforos, en la Figura 8 se observa que Aspergillus flavus mostró capacidad de producción, ya que viró el color del medio CAS-azul (en la parte superior) a tonos rojizos, a partir de los 30 días de crecimiento, mientras que Trichoderma longibrachiatum no presentó esa capacidad después de 45 días. La biodisponibilidad de P por los microorganismos se atribuye principalmente a la solubilización por excreción de ácidos orgánicos, pero otros procesos incluyen, la producción de sideróforos, oxidación directa, liberación de protones, producción de polisacáridos, simbiosis con micorrizas y, para el caso del P orgánico, la producción de enzimas como las fosfatasas y fitasas (Hallama et al. 2019, Rawat et al. 2021, Basílio et al. 2022). Bajo las condiciones evaluadas en este ensayo, se puede descartar para Trichoderma longibrachiatum (cepa CIA-UCR-29SP), la producción de sideróforos como mecanismo de biodisponibilidad de P ya que fue incapaz de virar el color del medio CAS-azul (Figura 8).
Conclusión
La presente investigación muestra que la inoculación con los hongos solubilizadores de P, Aspergillus flavus (cepa CIA-UCR-20SP) y Trichoderma longibrachiatum (cepa CIA-UCR-29SP), puede afectar positivamente la FBN, los contenidos de P foliar y el crecimiento de las plantas de soya.
Las leguminosas son particularmente dependientes de una adecuada nutrición fosfórica, debido entre otras razones, al alto costo energético que supone la FBN, por esto, una adecuada disponibilidad de P es fundamental para el éxito de la simbiosis y se debe contemplar al utilizar leguminosas, para este fin, una vía ecológicamente viable es la biodisponibilidad microbiológica de fósforo a partir de fuentes poco solubles como la roca fosfórica o las inmovilizadas en los suelos.
Aprovechar los beneficios de los consorcios microbianos en los suelos, es una estrategia prometedora para impulsar la adquisición de nutrientes por las plantas, fomentar efectos sinérgicos beneficiosos entre los microorganismos, promover la calidad y salud de plantas y suelos.
Literatura Citada
Basílio, F; Días, T; Santana, M; Melo, J; Carvalho, L; Correia, P; Cruz, C. 2022. Multiple modes of action are needed to unlock soil phosphorus fractions unavailable for plants: The example of bacteria- and fungi-based biofertilizers. Applied Soil Ecology 178:1-11.
Cao, N; Nguyen, B; Van, T. 2017. Effects of Bradyrhizobia and Phosphate-solubilizing bacteria on soybean (Glycine max L. Merrill) cultivated on Ferrasols of Cujut district, DakNong province, Vietnam. Inter. J. Envir. & Agric.Res. (3):70-79.
Cassan, F; Perriga, D; Sgroya, V; Masciarellia, O; Pennab, C; Luna, V. 2009. Azospirillum brasilense Az39 and Bradyrhizobium japonicum E109, inoculated singly or in combination, promote seed germination and early seedling growth in corn (Zea mays L.) and soybean (Glycine max L.). European Journal of Soil Biology 45:28-35.
Cherkasov, N; Ibhadon, A; Fitzpatrick, P. 2015. A review of the existing and alternative methods for greener nitrogen fixation. Chemical Engineering and Processing: Process Intensification 90:24-33.
da Costa Leite, R; Hungria, M; da Costa Leite, R; Souza de Ávila, W; Barata da Silva, G. 2023. Co-inoculation of soybean with Bradyrhizobium spp. and amazonian strains of Trichoderma asperellum and Bacillus amyloliquefaciens increases the productivity and profitability of the crop. Crop Science 1-47. DOI: https://doi.org/10.1002/csc2.21091
Díaz, R; Hunter, A. 1978. Metodologías de muestreo de suelos, análisis químico de suelos y tejido vegetal y de investigación en invernadero. Turrialba, Costa Rica, CATIE. 2 p.
Edson Zilli, J; Sanches Pacheco, R; Gianluppi, V; Smiderle, O; Urquiaga, S; Hungría, M. 2021. Biological N2 fixation and yield performance of soybean inoculated with Bradyrhizobium. Nutr Cycl Agroecosyst 119:323-336.
El-Nahhal, Y. 2018. Nitrate Residues in Fruits, Vegetables and Bread Samples and Their Health Consequences. Health 10:487-501.
El-Nahrawy, S; Elbagory, M; El-Dein, O. 2020. Biocompatibility Effect of Bradyrhizobium japonicum and Trichoderma Strains on Growth, Nodulation and Physiological Traits of Soybean (Glycine max L.) under Water Deficit Conditions. Journal of Advances in Microbiology 20 (11):52-66.
Fernández, R; González-Reyes, D. 2014. En la espiral de la energía. Colapso del capitalismo global y civilizatorio. Volumen II. Madrid, España, Ecologistas en Acción. 449 p.
Giraldo, O. 2015. Agroecología y complejidad. Acoplamiento de la técnica a la organización ecosistémica. Polis 41:1-21.
Giraldo, O; Toro, I. 2020. Afectividad ambiental: sensibilidad, empatía, estéticas del habitar. Chetumal, Quintana Roo, México, El Colegio de la Frontera Sur. 172 p.
Gyaneshwar, P; Naresh Kumar, G; Parekh, L; Poole PS. 2002. Role of soil microorganisms in improving P nutrition of plants. Plant Soil 245:83-93.
Hallama, M; Pekrun, C; Lambers, H; Kandeler, E. 2019. Hidden miners -the roles of cover crops and soil microorganisms in phosphorus cycling through agroecosystems. Plant Soil 434:7-45.
Henríquez, C; Cabalceta, G. 2012. Guía práctica para el estudio introductorio de los suelos con un enfoque agrícola. San José, Costa Rica, Asociación Costarricense de la Ciencia del Suelo. 111 p.
Hungria, M; Nogueira, M; Araujo, R. 2013. Co-inoculation of soybeans and common beans with rhizobia and azospirilla: strategies to improve sustainability. Biol Fertil Soils 49:791-801.
Islam, M; Ahmed, M; Hossain, M; Akter, H; Aktar S. 2017. Response of soybean to Rhizobium biofertilizer under different levels of phosphorus. Progressive Agriculture 28(4):302-315.
Kazemi, S; Ghaleshi, S; Ghanbari, A; Kianoush, G. 2005. Effects of planting date and seed inoculation by the bacteria on the yield and yield components of two soybean varieties. Agri. Sci. Nat. Resour. 12(4):20-26.
Kibblewhite, M; Ritz, K; Swift, M. 2008. Soil health in agricultural systems. Philos. Trans. R Soc Lond B Biol Sci. 363(1492):685-701.
Kleinert, A; Venter, M; Kossmann, J; Valentinea A. 2014. The reallocation of carbon in P deficient lupins affects biological nitrogen fixation. Journal of Plant Physiology 171:1619-1624.
Lamyaa, A; El-Rahman, A; Sayed, D; Ewais, M. 2019. Effect of Different Sources of Phosphorus and Bio Fertilizers on Yield and Seeds Quality of Soybean. Egypt Menoufia J. Soil Sci. 4:15-35.
Li, Y; Li, Q; Guan, G; Chen, S. 2020. Phosphate solubilizing bacteria stimulate wheat rhizosphere and endosphere biological nitrogen fixation by improving phosphorus content. PeerJ 8: e9062. DOI: 10.7717/peerj.9062
Lloret-Pastor, F. 2021. Fijación biológica del nitrógeno y síntesis del nitrato: usos y aplicaciones. An. Quím. 117(3):203-208.
Lyu, D; Zajonc, J; Pagé, A; Tanney, C; Shah, A; Monjezi, N; Msimbira, L; Antar, M; Nazari, M; Backer, R. 2021. Plant Holobiont Theory: The Phytomicrobiome Plays a Central Role in Evolution and Success. Microorganisms 9:675.
Maluk, M; Madeline Giles, M; Wardell,G, Akramin, A; Ferrando-Molina, F, Murdoch, A; Barros, M; Beukes, C; Vasconcelos, M; Harrison, E; Daniell, T, Quilliam, R; Iannetta, P; James, E. 2023. Biological nitrogen fixation by soybean (Glycine max [L.] Merr.), a novel, high protein crop in Scotland, requires inoculation with non-native bradyrhizobia. Front. Agron. Sec. Plant-Soil Interactions 5:1196873.
Milagres, A; Machuca, A; Napoleao, D. 1999. Detection of siderophore production from several fungi and bacteria by a modification of chrome azurol S (CAS) agar plate assay. Journal of Microbiological Methods 37:1-6.
MLA-CIA-UCR (Manual de Laboratorio de Microbiología Agrícola-Centro de Investigaciones Agronómicas Universidad de Costa Rica). 2015. Técnicas para el recuento de Microorganismos. San José, Costa Rica, Universidad de Costa Rica. 47 p.
Morin, E. 2002. El método II. La vida de la vida 5 ed. Madrid, España, Ediciones Catedra. 529 p.
Olivera, M; Iribarne, C; Lluch, C. 2002. Effect of phosphorus on nodulation and N fixation by bean (Phaseolus vulgaris). Proceedings of the 15th International Meeting on Microbial Phosphate Solubilization. Salamanca, Spain, Salamanca University. s. p.
Osorio, N; Habte, M. 2001. Synergistic influence of an arbuscular mycorrhizal fungus and a P solubilizing fungus on growth and P uptake of Leucaena leucocephala in a Oxisol. Arid Land Research and Management 15:263-274.
Parewa, H; Meena, V; Jain, L; Choudhary, A. 2018. Sustainable Crop Production and Soil Health Management Through PlantGrowth-Promoting Rhizobacteria. In Meena, VS. (ed.). Role of Rhizospheric Microbes in Soil, Springer Nature Singapore Pte Ltd. p. 299-329.
Patiño-Torres, C; Sanclemente-Reyes, O. 2014. Los microorganismos solubilizadores de fósforo (MSF): una alternativa biotecnológica para una agricultura sostenible. Entramado 10(2):288-297.
Rahmani, A; Rastin, S; Sajadi, A. 2000. Investigate the possibility of predicting the need of inoculation of soybeen, based on the determine number of Bradyrhizobium japonicum bacteria and index of availability of soil nitrogen. Soil Water J. 12(7):21-32.
Rattan, L; Claire, Ch; Philippe, C. 2017. Letter to the Editor: Answer to the Viewpoint “Sequestering Soil Organic Carbon: A Nitrogen Dilemma. Environ. Sci. Technol. 51:11502-11502.
Rawat, P; Das, S; Shankhdhar, D; Shankhdhar, S. 2021. Phosphate-Solubilizing Microorganisms: Mechanism and Their Role in Phosphate Solubilization and Uptake. Journal of Soil Science and Plant Nutrition 21:49-68.
Richardson, A; Barea, J; McNeill, A; Prigent-Combaret, C. 2009. Acquisition of phosphorus and nitrogen in the rhizosphere and plant growth promotion by microorganisms. Plant Soil 321:305-339.
Rosas, S; Rovera, M; Andres, J; Correa, N. 2002. Effect of phosphorous solubilizing bacteria on the rhizobia-legume symbiosis. Proceedings of the 15th International Meeting on Microbial phosphate Solubilization. Salamanca, Spain, Salamanca University.
Saranraj, P; Sivasakthivelan, P; Al-Tawaha, A; Sudha, A; Al-Tawaha, A; Sirajuddin, S; Hastang. 2021. Diversity and evolution of Bradyrhizobium communities relating to Soybean cultivation: A review. Earth and Environmental Science 788:012208.
Savci, S. 2012. An Agricultural Pollutant: Chemical Fertilizer International Journal of Environmental Science and Development 3(1):77-80.
Schindler, D, Hecky, R, Findlay, D, Stainton, M; Parker, B; Paterson, M; Beaty, K; Lyng, M; Kasian, S. 2008. Eutrophication of lakes cannot be controlled by reducing nitrogen input: Results of a 37-year whole-ecosystem experiment. PNAS 105(32):11254-11258.
Singh, M; Dotaniya, M; Mishra, A; Dotaniya, C; Regar, K; Lata, M. 2016. Role of Biofertilizers in Conservation Agriculture. Conservation Agriculture 113-134. DOI: http://dx.doi.org/10.1007/978-981-10-2558-7_4
Smercina, D; Evans, S; Friesen, M; Tiemann, L. 2019. To fix or not to fix: controls on free-living nitrogen fixation in the rhizosphere. Appl Environ Microbio l85:02546-18. DOI: https://doi .org/10.1128/AEM.02546-18
Soumare, A; Diedhiou, A; Thuita, M; Hafidi, M; Ouhdouch, Y; Gopalakrishnan, S; Kouisni, L. 2020. Exploiting Biological Nitrogen Fixation: A Route Towards a Sustainable Agriculture Abdoulaye Plants 9:1-22.
Stajković-Srbinović, O; Kuzmanović, D; Rasulić, N; Knežević, M; Ugrenović, V; Buntić, A; Dušica, D. 2021. Effect of inoculation with Bradyrhizobium and phosphate solubilizing bacteria on soybean seed yield and composition. Zemljiste I Biljka 70(2):56-66.
Sukiman, H; Lekatompessy, S; Widowati T; Simarmata, R. 2019. Application of arbuscular mycorrhizal fungi in combination with nitrogen fixing bacteria and other potential soil microbes as biofertilizer for soybean plant. IOP Conf. Series: Earth and Environmental Science 308 012059. DOI:10.1088/1755-1315/308/1/012059
Sun, W; Shahrajabian, M; Cheng, Q. 2021. Nitrogen Fixation and Diazotrophs-A Review. Rom Biotechnol Lett. 26(4):2834-2845.
Vance, E; Brookes, P; Jenkinson, D. 1987. An extraction method for measuring soil microbial biomass C. Soil Biology and Biochemistry 19(6):703-707.
Vargas, P; Castro, L. 2019. Aislamiento y Evaluación de Microorganismos Solubilizadores de Fósforo de Andisoles de Costa Rica. Agronomía Costarricense 43(1):47-68.
Zarei, I; Sohrabi, Y; Heidari, G; Jalilian, A; Mohammadi, K. 2012. Effects of biofertilizers on grain yield and protein content of two soybean (Glycine max L.) cultivars African Journal of Biotechnology 11(27):7028-7037.